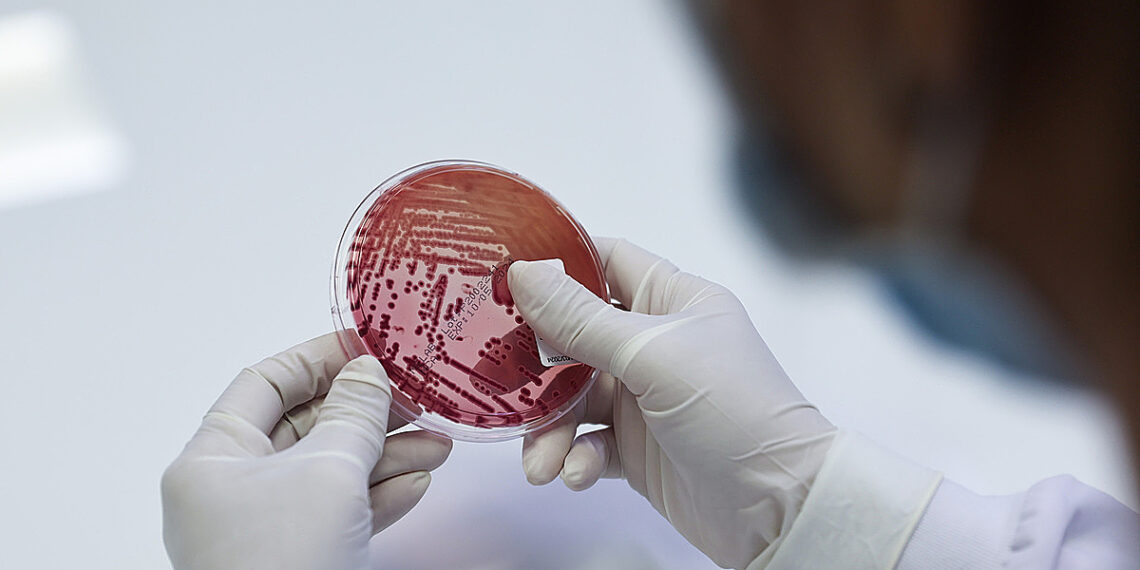

TP HCMNgười đàn ông 32 tuổi tiểu buốt, rát và chảy mủ trắng đục từ niệu đạo sau khoảng 10 ngày trải nghiệm massage kích dục bằng miệng.
Ngày 7/9, TS.BS.CK2 Trà Anh Duy, Trung tâm Sức khỏe Nam giới Men’s Health, cho biết xét nghiệm PCR nước tiểu và dịch niệu đạo phát hiện dương tính vi khuẩn gây bệnh lậu Neisseria gonorrhoeae. Sau điều trị kháng sinh theo phác đồ 7 ngày, các triệu chứng tiểu buốt và tiết dịch biến mất. Tuy nhiên, bệnh nhân vẫn tiếp tục ghi nhận giảm ham muốn tình dục kéo dài suốt 2 tháng, ảnh hưởng lớn đến đời sống hôn nhân.
Lậu là bệnh lây truyền qua đường tình dục phổ biến, không chỉ qua giao hợp âm đạo hoặc hậu môn mà cả qua quan hệ bằng miệng. Điều này lý giải vì sao bệnh nhân không quan hệ tình dục hoàn toàn, chỉ có tiếp xúc miệng – sinh dục, vẫn bị lây nhiễm. Theo một nghiên cứu, tỷ lệ lây nhiễm lậu qua đường miệng chiếm tới 23,4% trong số các ca được chẩn đoán, cho thấy đường lây này không hề hiếm.
Trường hợp giảm ham muốn tình dục sau nhiễm lậu như bệnh nhân này không phải cá biệt. Stress sau điều trị, lo sợ tái phát, mặc cảm tội lỗi và thay đổi tâm lý đều góp phần gây rối loạn chức năng tình dục. Nghiên cứu của Hughes và cộng sự trên Journal of Psychosomatic Research, có đến 18% nam giới sau khi mắc bệnh lây truyền qua đường tình dục giảm ham muốn tình dục kéo dài hơn 6 tuần, 7% có dấu hiệu rối loạn cương dương.

Xét nghiệm cho bệnh nhân. Ảnh: Quỳnh Trần
Bác sĩ khuyến cáo, khi có dấu hiệu bất thường, người bệnh cần đi khám và xét nghiệm sớm để tránh biến chứng viêm tinh hoàn, viêm mào tinh hoàn hay vô sinh do tắc nghẽn đường dẫn tinh. Ngoài điều trị kháng sinh, bệnh nhân nên được hỗ trợ tâm lý để giảm lo âu và khôi phục đời sống tình dục. Việc điều trị phải tiến hành đồng thời ở cả bệnh nhân và bạn tình để ngăn lây nhiễm chéo.
Lê Phương